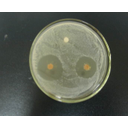
Show Tác dụng của kháng sinh Image

2. Dịch tễ học và miễn dịch
2.
Dịch tễ học và miễn dịch
2.1. Nhiễm khuẩn
a/ Khái niệm
NK
là khi có VSV gây bệnh xâm nhập vào mô của cơ thể có thể xuất hiện hoặc
không xuất hiện bệnh.
Sự kí sinh
của VSV trên cơ thể nhưng không xâm nhập vào mô thì không gọi là nhiễm
trùng. Các VSV phần lớn không gây bệnh, chỉ có một số có khả năng gây
bệnh khi gặp điều kiện thuận lợi, gọi là các VSV gây bệnh cơ hội, một
số có lợi cho cơ thể, gọi là VSV cộng sinh.
b/ Phân loại nhiễm khuẩn
-
Bệnh nhiễm trùng: Khi VSV xâm
nhập vào cơ thể và gây loạn cơ chế điều hòa cơ thể. Biểu hiện các dấu
hiệu nhiễm trùng như sốt, ho, đau, mệt mỏi, rối loạn tiêu hóa, tuần hoàn, hô hấp…
gọi là các triệu chứng lâm sàng. Bệnh nhiễm trùng được chia làm 2
loại:
+ Bệnh nhiễm trùng cấp tính: Triệu chứng bệnh rõ rệt, thường xuất hiện trong 1 thời gian ngắn,
sau đó bệnh nhân khỏi bệnh hoặc tử vong, một số trường hợp có thể
chuyển thành mãn tính. Sau khi khỏi bệnh, một số trường hợp thu được miễn dịch
như: sởi, thương hàn, bạch hầu.
+ Bệnh nhiễm trùng mãn tính: Triệu chứng không dữ dội, tiến triển chậm, lâu, thường không gây được
miễn dịch nhưng kéo dài. Bệnh có thể chuyển từ cấp tính sang mãn tính hay ngược
lại phụ thuộc vào phản ứng của cơ thể.
-
Nhiễm trùng thể ẩn: Người bị
bệnh nhiễm trùng nhưng không có các dấu hiệu lâm sàng tuy nhiên có những thay đổi
về công thức máu.
-
Nhiễm trùng tiềm tàng: VSV gây
bệnh tồn tại ở một số nơi nào đó trong cơ thể, đến khi có điều kiện thuận
lợi có thể gây ra các dấu hiệu nhiễm
trùng rõ rệt.
c/ Các
nhân tố gây nhiễm khuẩn
* Các
vi sinh vật gây bệnh: là một nhân tố quan trọng của quá trình nhiễm khuẩn,
khả năng gây bệnh của các VSV phụ thuộc vào:
- Động lực của các vi sinh vật: được ở
khả năng bám vào tế bào chủ của các vi sinh vật; sự xâm nhập của nó trong tế
bào; khả năng thải ra độc tố...
- Số lượng vi sinh vật: phải có số lượng
nhất định.
- Đường xâm nhập: phải xâm nhập đúng đường.
*
Sự đề kháng của cơ thể
VSV gây bệnh sau khi vào cơ thể & có đủ điều kiện gây bệnh (độc
lực, đủ số lượng, xâm nhập đúng đường) nhưng bệnh có xảy ra hay không còn phụ
thuộc vào sức đề kháng của cơ thể, thường chia làm 2 loại hệ thống: không đặc
hiệu và đặc hiệu.
-
Hệ thống phòng ngự không đặc hiệu (Miễn dịch không đặc hiệu – miễn dịch tự nhiên)
Là
hàng rào vốn có của cơ thể nó có tác dụng ngăn cản ngay lập tức
mọi sự xâm nhập của VSV. Hệ thống nầy gồm có:
+ Da và
niêm mạc: Da và niêm
mạc là hàng rào đầu tiên ngăn cản sự xâm nhập của VSV vào cơ thể. Tế
bào da và niêm mạc phủ bởi 1 lớp chất nhầy; Sự bài tiết mồ hôi, nước mắt,
nước bọt và các dịch tiêu hóa.
+ Bạch cầu diệt khuẩn: nếu các vi khuẩn xâm nhập được vào máu trong huyết
thanh có sẵn các chất bảo vệ đặc biệt (axilin) và bạch cầu đa nhân trung tính
có khả năng biến hình ôm lấy các vi khuẩn gây bệnh và tiêu diệt chúng.
+ Các yếu tố gây miễn dịch
khác: Miễn dịch chủng loại; Miễn dịch bẩm sinh; Miễn dịch sinh hoạt.
-
Hệ thống phòng ngự đặc hiệu:
Cơ thể có được sau khi đã tiếp xúc với 1 VSV nào đó. Sự tiếp xúc đó làm cơ
thể sinh ra kháng thể đặc hiệu.
+ Miễn
dịch dịch thể: Kháng thể là nhân tố trung tâm của miễn dịch này. Cơ chế cơ bản chống nhiễm
trùng là sự kết hợp đặc biệt với kháng nguyên của vi sinh vật.
+ Miễn dịch tế bào: Chủ yếu là tế bào limphô và đại thực bào trong máu tiêu diệt mầm bệnh.

Cơ thể có bị nhiễm trùng hay không
phụ thuộc:
+ Sự tương
quan giữa VSV gây bệnh và sự đề kháng của
cơ thể.
+ Sự đề kháng của cơ thể với hai hệ thống trên bổ
sung, hỗ trợ và không tách rời nhau.
2.2.
Truyền nhiễm
a/ Khái niệm: Bệnh TN là những
bệnh do VSV gây bệnh trực tiếp hoặc gián tiếp, truyền từ người này
sang người khác, hoặc từ động vật sang người.
Biểu
hiện của bệnh phụ thuộc vào 3 yếu tố: Tác nhân gây bệnh, cơ thể con người và đường
TN.
b/ Tính chất bệnh truyền nhiễm
-
Tính đặc hiệu: Mỗi bệnh truyền nhiễm do
1 loại VSV nhất định gây ra.
-
Tính lây truyền: Bệnh lan truyền từ cơ thể này đến cơ thể khác và làm cho nhiều
người bị bệnh, gây dịch.
-
Tính chu kì: Bình thường bệnh diễn biến qua các thời kì ủ bệnh, khởi phát, toàn
phát và lui bệnh.
-
Tính miễn dịch đặc hiệu: Khi mầm bệnh xâm nhập cơ thể sẽ có hiện tượng kích
thích các tế bào sinh kháng thể chống lại, thời gian được miễn dịch khác nhau
tùy cơ thể, tùy bệnh.
c/ Phân loại bệnh truyền nhiễm
Dựa vào đường lan truyền, bệnh truyền nhiễm được phân chia thành 4
loại:
- Bệnh truyền nhiễm qua đường hô hấp: Gây tử vong cao nhất trong
số các bệnh trẻ em; Bệnh lây trực tiếp từ người bệnh sang người
lành khi tiếp xúc do ho, hắc hơi, nói… hạt nước bọt, đờm rãi bị bốc hơi nên nhẹ
và bay lơ lửng trong không khí và trẻ hít phải; Bệnh lây trực tiếp qua vật
trung gian làm ô nhiễm quần áo, chăn chiếu, bụi bặm khi tung dỡ quần áo, quét
nhà, nhiều bụi bẩn làm lan truyền VSV hoặc
dùng khăn chung có thể lây bệnh.
* Phòng bệnh: Vệ sinh môi trường sống, vệ sinh nền nhà, các trang thiết bị, làm thoáng khí; Đeo khẩu trang khi làm VS, phơi quần áo, chăn màn, chiếu ra ánh sáng; Trồng cây xanh, không khạc nhổ bừa bãi...Tiêm vacxin.
- Bệnh truyền nhiễm qua
đường tiêu hóa: Các VSV do người bệnh thải
ra ngoài theo phân, nước tiểu, chất nôn vào cơ thể người lành qua thức ăn, nước
uống bị nhiễm khuẩn, bệnh có thể lây trực tiếp từ người bệnh, hoặc mới khỏi bệnh
sang người lành. VSV này tồn tại qua
vật trung gian như: nước, thức ăn, đồ vật, chân vòi của ruồi, gián.
* Phòng bệnh: Vệ sinh ăn uống: Dùng nước
sạch để ăn uống và sinh hoạt; Vệ sinh môi trường: Quản lí phân tốt. Bảo quản vệ
sinh thực phẩm; Vệ sinh cá nhân; Sử dụng vacxin phòng bệnh.
- Bệnh truyền nhiễm qua
đường máu: Do các loại côn trùng châm đốt
người bệnh hoặc động vật bị bệnh rồi truyền bệnh khi đốt người lành. Vật trung gian truyền bệnh là: muỗi,
cháy rận.... Bệnh có thể lây truyền
qua đường tiêm truyền: viêm gan, AIDS…
* Phòng bệnh: Điều trị sớm những người mắc bệnh; Diệt côn trùng, Không để côn trùng đốt; Cải tạo môi trường; Vacxin phòng bệnh.
- Bệnh truyền nhiễm qua
da và niêm mạc: Mầm bệnh xâm nhập qua da và
niêm mạc bị tổn thương hoặc không bị tổn thương, lây trực tiếp hoặc gián tiếp
qua vật trung gian truyền bệnh.
* Phòng bệnh: Cách
li, cắt đứt đường lây, điều trị sớm những người bị bệnh; Vệ sinh sạch sẽ, diệt
côn trùng và vật trung gian bị bệnh; Vacxin phòng bệnh.
2.3. Miễn dịch
a/ Khái niệm
Miễn
dịch là sức đề kháng của cơ thể đối
với VSV gây bệnh hay là khả năng chống đỡ của cơ thể với hiện tượng nhiễm
khuẩn.
b/ Phân loại miễm dịch
- Miễn dịch chủ động: Miễn dịch chủ động tự nhiên và miễn dịch chủ
động nhân tạo.
+ Miễn dịch chủ động tự nhiên: Cơ thể có khả năng miễn dịch đối với một số bệnh
sau khi đã khỏi như: Sởi, quai bị. Tùy theo bệnh thời gian miễn dịch có
thể lâu hoặc ngắn.
+ Miễn dịch chủ động nhân tạo: Được hình thành do sử dụng phương pháp tiêm chủng.
Thời gian miễn dịch được hình thành ngắn hơn loại trên, nên cần tiêm chủng nhắc
lại.
- Miễn dịch bị động: Miễn dịch bị động tự nhiên và miễn dịch bị
động nhân tạo.
+ Miễn dịch bị động tự nhiên: Được hình thành do mẹ truyền sang con qua máu và sữa mẹ.
+ Miễn dịch bị động nhân tạo: Được hình thành nhờ sử dụng huyết thanh kháng
độc sau khi cơ thể đã mắc bệnh. Huyết thanh có tác dụng ngay nhưng
lại chóng bị đào thải ra ngoài nên cần có tiêm chủng hỗ trợ.
* Một số khái niệm khác:
- Kháng nguyên: Là những
chất khi vào cơ thể có tác dụng kích thích cơ thể sinh ra kháng thể
chống bệnh. Đó là VK, VR, ngoại độc tố, protein lạ. Kháng nguyên thúc đẩy
cơ thể tổng hợp ra kháng thể tương ứng.
- Kháng thể: Là những chất do cơ thể tổng hợp được dưới sự kích thích của kháng nguyên. Mỗi kháng thể chỉ phản ứng đặc hiệu với 1 kháng nguyên tương ứng.
+ Sự hình thành kháng thể phụ thuộc vào chủng loại, vào
tính chất di truyền của cơ thể, vào tuổi, hoạt động của hệ thần kinh, nội
tiết và điều kiện dinh dưỡng và nhất là điều kiện kháng nguyên.
+ Mỗi kháng nguyên chỉ gây được cho cơ thể 1 kháng thể đặc
hiệu. Khi cần gây miễn dịch đối với nhiều bệnh, người ta trộn hỗn hợp
nhiều kháng nguyên vào 1 dung dịch để tiêm.
-
Vacxin: Dùng vacxin là đưa vào cơ
thể một chất có nguồn gốc từ VSV gây bệnh đã được bào chế đảm bảo độ an toàn cần
thiết, làm cho cơ thể tự tạo ra miễn dịch chống lại tác nhân gây bệnh.
+ Tiêm chủng là
đưa vacxin vào cơ thể, kích thích cơ thể sinh ra kháng thể chống bệnh tương ứng.
* Các yêu cầu đối với tiêm chủng
+ Tỉ lệ tiêm chủng: Tiêm chủng cần phải tiến hành trên phạm vi rộng, đạt
tỉ lệ 80% trở lên.
+ Đối tượng tiêm chủng: Tất cả những người có nguy cơ bị mắc bệnh mà chưa có
MD. Trẻ em là đối tượng đáng quan tâm. Tạm hoãn đối với những người đang mắc
bệnh cấp tính, phụ nữ có thai, không tiêm cho người mắc bệnh mãn tính như: Lao,
đái đường, viêm thận mãn, tim.
+ Thời gian tiêm chủng: Thông thường, sau khi tiêm chủng từ 7-10 ngày,
cơ thể mới hình thành miễn dịch. Vì vậy, việc tiêm chủng phải tiến
hành trước mùa dịch xảy ra. Đảm bảo khoảng cách giữa các lần tiêm chủng,
chú ý tiêm chủng nhắc lại.
+ Vacxin đưa vào cơ thể đúng đường, đúng liều. Cần chú ý thận trọng
xử lý các phản ứng do vacxin.
+ Lịch tiêm chủng – (SV tự nghiên cứu)
CÂU HỎI ÔN TẬP
Câu 1: Thế nào là bệnh truyền nhiễm? Nêu cách phân loại bệnh truyền nhiễm thường gặp ở trẻ em.
Câu 2: Thế nào là miễn dịch? Phân loại các loại miễn dịch thường gặp ở trẻ.